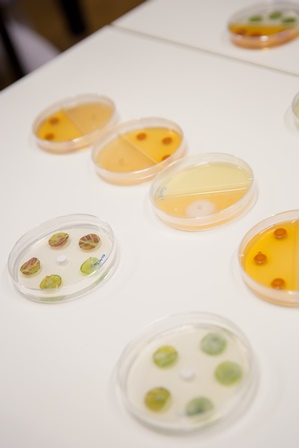

Biologie
14. November 2018
Tauche ein in die Welt der Lebewesen
Die Welt der Lebewesen ist extrem vielfältig: sie umfasst mikroskopisch kleine Bakterien, majestätische Wale oder auch alle Pflanzen.
In praktischen Workshops erhielten wir faszinierende Einblicke in diese Welt. Bei einem spannenden Experiment generierten wir den Bauplan einer Tomate. Wir erforschten, wie Bakterien miteinander kommunizieren und Pflanzen beim Wachsen helfen. Mit dem Mikroskop sind wir den Geheimnissen der Würmer auf die Spur gekommen. Und im Botanischen Garten der Universität Fribourg begaben wir uns auf die Suche nach Wunderkräutern.
Ein herzliches Dankeschöne an Dr. Chantal Wicky und ihr Team für diesen tollen Nachmittag!